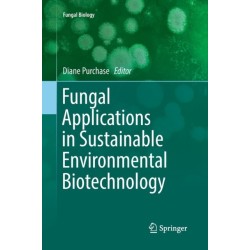
Fungal Applications in Sustainable Environmental Biotechnology

Ingen varer
- Anvendt databehandling
- Computere og hardware
- Databaser
- Datakommunikation og computernetværk
- Datasikkerhed
-
Digital livsstil
- Computerspil / onlinespil: strategivejledninger
- Digital musik og lyd: Guides og brugervejledninger
- Digital photography: consumer / user guides
- Digital TV og mediacentre: Guides og brugervejledninger
- Digital video: Guides og brugervejledninger
- E-bogslæsere, tablets og andre bærbare enheder: Guides og brugervejledninger
- E-mail: Guides og brugervejledninger
- Internetvejledninger og Internettjenester
- Mobiltelefoner og smarttelefoner: Guides og brugervejledninger
- Onlinesikkerhed og -adfærd
- Personlig planlægning: software og apps
- Virtuelle assistenter: brugsvejledninger
- Grafisk IT og digitale medier
- Informatik
- Informationsteknologi: generelle emner
- IT-certificering
- Operativsystemer
- Praktisk brug af informationsteknologi
-
Programmering / softwareudvikling
- Agil programmering
- Algoritmer og datastrukturer
- Aspektorienteret programmering
- Databaseprogrammering
- Extreme programming (XP)
- Funktionel programmering
- Grafisk programmering
- Kompilatorer og fortolkere
- Mobile og håndholdte enheders programmering. Programmering af apps
- Netværksprogrammering
- Objektorienteret programmering
- Programmering: Macintosh
- Programmering: Microsoft
- Programmeringssprog og scriptsprog
- Programmeringsteknikker
- Softwareudvikling
- Spiludvikling og spilprogrammering
- Webprogrammering
- Virksomhedssoftware
Databehandling og informationsteknologi
-
Bemærk: Kan ikke leveres før jul.
Memorized Discrete Systems and Time-delay (Bog, Paperback / softback, Engelsk)This book examines discrete dynamical systems with memory—nonlinear systems that exist extensively in biological organisms and financial and economic organizations, and time-delay systems that can be discretized into the memorized, discrete dynamical systems.
Levering: Skaffevare (forvent 14 - 30 hverdage) -
Bemærk: Kan ikke leveres før jul.
K-Best Decoders for 5G+ Wireless Communication (Bog, Paperback / softback, Engelsk)The authors explain topics gradually, stepping from basic MIMO detection to optimized schemes for both hard and soft domain MIMO detection and also to the... Læs mere
Levering: Skaffevare (forvent 14 - 30 hverdage) -
Bemærk: Kan ikke leveres før jul.
Fiber-Wireless Convergence in Next-Generation Communication Networks: Systems, Architectures, and Management (Bog, Paperback / softback, Engelsk)The editors discuss Fi-Wi technologies at the three major network levels involved in the path... Læs mere
Levering: Skaffevare (forvent 14 - 30 hverdage) -
Bemærk: Kan ikke leveres før jul.
Decision Diagrams for Optimization (Bog, Paperback / softback, Engelsk)The authors present chapters on the use of decision diagrams for combinatorial optimization and constraint programming, with attention to general-purpose solution... Læs mere
Levering: Skaffevare (forvent 14 - 30 hverdage) -
Bemærk: Kan ikke leveres før jul.
Fungal Applications in Sustainable Environmental Biotechnology (Bog, Paperback / softback, Engelsk)Levering: Skaffevare (forvent 14 - 30 hverdage) -
Bemærk: Kan ikke leveres før jul.
Models of Computation (Bog, Paperback / softback, Engelsk)This book presents in their basic form the most important models of computation, their basic programming paradigms, and their mathematical descriptions, both concrete and abstract.
Levering: Skaffevare (forvent 14 - 30 hverdage) -
Bemærk: Kan ikke leveres før jul.
Cool Math for Hot Music: A First Introduction to Mathematics for Music Theorists (Bog, Paperback / softback, Engelsk)This textbook is a first introduction to mathematics for music theorists, covering basic topics such as sets and functions, universal properties, numbers and recursion, graphs, groups, rings, matrices and modules, continuity, calculus, and gestures.
Levering: Skaffevare (forvent 14 - 30 hverdage) -
Bemærk: Kan ikke leveres før jul.
Recent Advances in Evolutionary Multi-objective Optimization (Bog, Paperback / softback, Engelsk)This book covers the most recent advances in the field of evolutionary multiobjective optimization. In addition to theory and methodology,... Læs mere
Levering: Skaffevare (forvent 14 - 30 hverdage) -
Bemærk: Kan ikke leveres før jul.
Intelligence Systems in Environmental Management: Theory and Applications (Bog, Paperback / softback, Engelsk)Levering: Skaffevare (forvent 14 - 30 hverdage) -
Bemærk: Kan ikke leveres før jul.
System Architecture: An Ordinary Engineering Discipline (Bog, Paperback / softback, Engelsk)Levering: Skaffevare (forvent 14 - 30 hverdage) -
Bemærk: Kan ikke leveres før jul.
Artificial Neural Networks: A Practical Course (Bog, Paperback / softback, Engelsk)This book provides comprehensive coverage of neural networks, their evolution, their structure, the problems they can solve, and their applications. The... Læs mere
Levering: Skaffevare (forvent 14 - 30 hverdage) -
Bemærk: Kan ikke leveres før jul.
Computer Supported Qualitative Research (Bog, Paperback / softback, Engelsk)Systematization of approaches with Qualitative Studies (literature review, integrating results, aggregation studies, meta -analysis, meta- analysis of qualitative... Læs mere
Levering: Skaffevare (forvent 14 - 30 hverdage)

 for at udvide
kategorilisten.
for at udvide
kategorilisten.